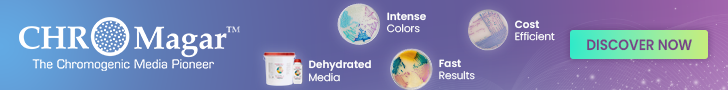
CHROMagar trade
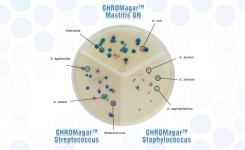
CHROMagar chromogenic media for mastitis diagnosis
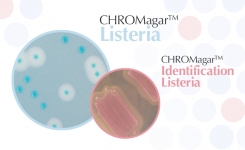
Find Listeria mono from Listeria spp on chromogenic media
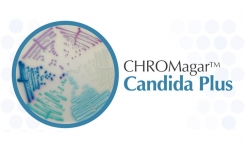
chromogenic media for candida auris from chromagar

Globally, 2 billion people still lack access to safe drinking water, leading to over 500,000 deaths every year from waterborne diseases.¹ Among all microbial indicators, Escherichia coli (E. coli) remains the most critical marker of fecal contamination and is therefore essential for assessing water safety. According to World Health Organization (WHO) guidelines,² drinking water is considered safe only when no E. coli is detected in a 100 mL sample.
However, drinking water is not the only water that requires careful monitoring. Recreational waters and treated wastewater must also be tested—here, the challenge lies not merely in the presence of E. coli and coliforms, but in their concentration. This is why Most Probable Number (MPN) testing is used to quantify bacterial levels accurately. Regular, reliable monitoring is vital to maintain water quality, protect public health, and prevent outbreaks.
AquaCHROM™ ECC is a chromogenic culture medium specifically engineered for the detection, differentiation, and quantification of E. coli and coliform bacteria in 100 mL water samples. AOAC-certified and aligned with international standards, it delivers precise, dependable results across a broad range of water types—making it a robust solution for routine water quality monitoring.
How does it work?
There are two testing methods :

Check our explanatory video for a demo.
Why choose AquaCHROM ECC? :
- Fast results - 18–24 hours, even at room temperature
- Easy to read thanks to distinctive color differentiation
- No UV lamp required
- High performing - sensitivity and specificity of ≈100%3
- AOAC certified
- Environmentally friendly and easy to use - reusable dispenser and sterilizable 48-well plate
Our product’s performance is not only trusted in the field, but solid scientific data also backs it. Visit the product page and explore all supporting publications, studies and full performance reports.
Explore our comprehensive range of chromogenic culture media, specifically designed to support water analysis.
Sources:
- UN-Water. Summary progress update 2021: SDG 6 – water and sanitation for all. WHO, consulted on January 2025.
- Guidelines for drinking-water quality, WHO, consulted on January 2025.
- Evaluation Of AquaCHROMTM ECC, A New Chromogenic Culture Broth For The Detection Of E.coli And Other Coliforms, Lerner et al., 2013. ASM.